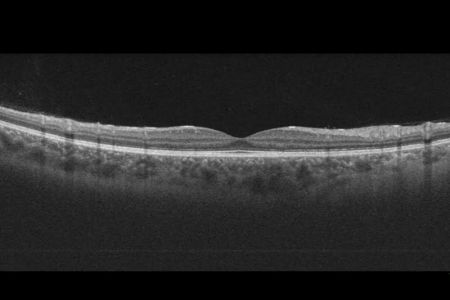

COMITATO MACULA
Ultime Notizie
Prevenzione e salute, controlli gratuiti alla Fiera di Sant’Agata per la vista degli over 55
31/01/2025
di M.C.
Farmaci per la maculopatia, il comitato dei pazienti chiede l’approvazione in Europa
19/12/2024
di Matteo Cantile

Spezia-Sampdoria 2-0: cronaca e tabellino della partita
06/04/2025
di steris
Iscriviti alla Newsletter






